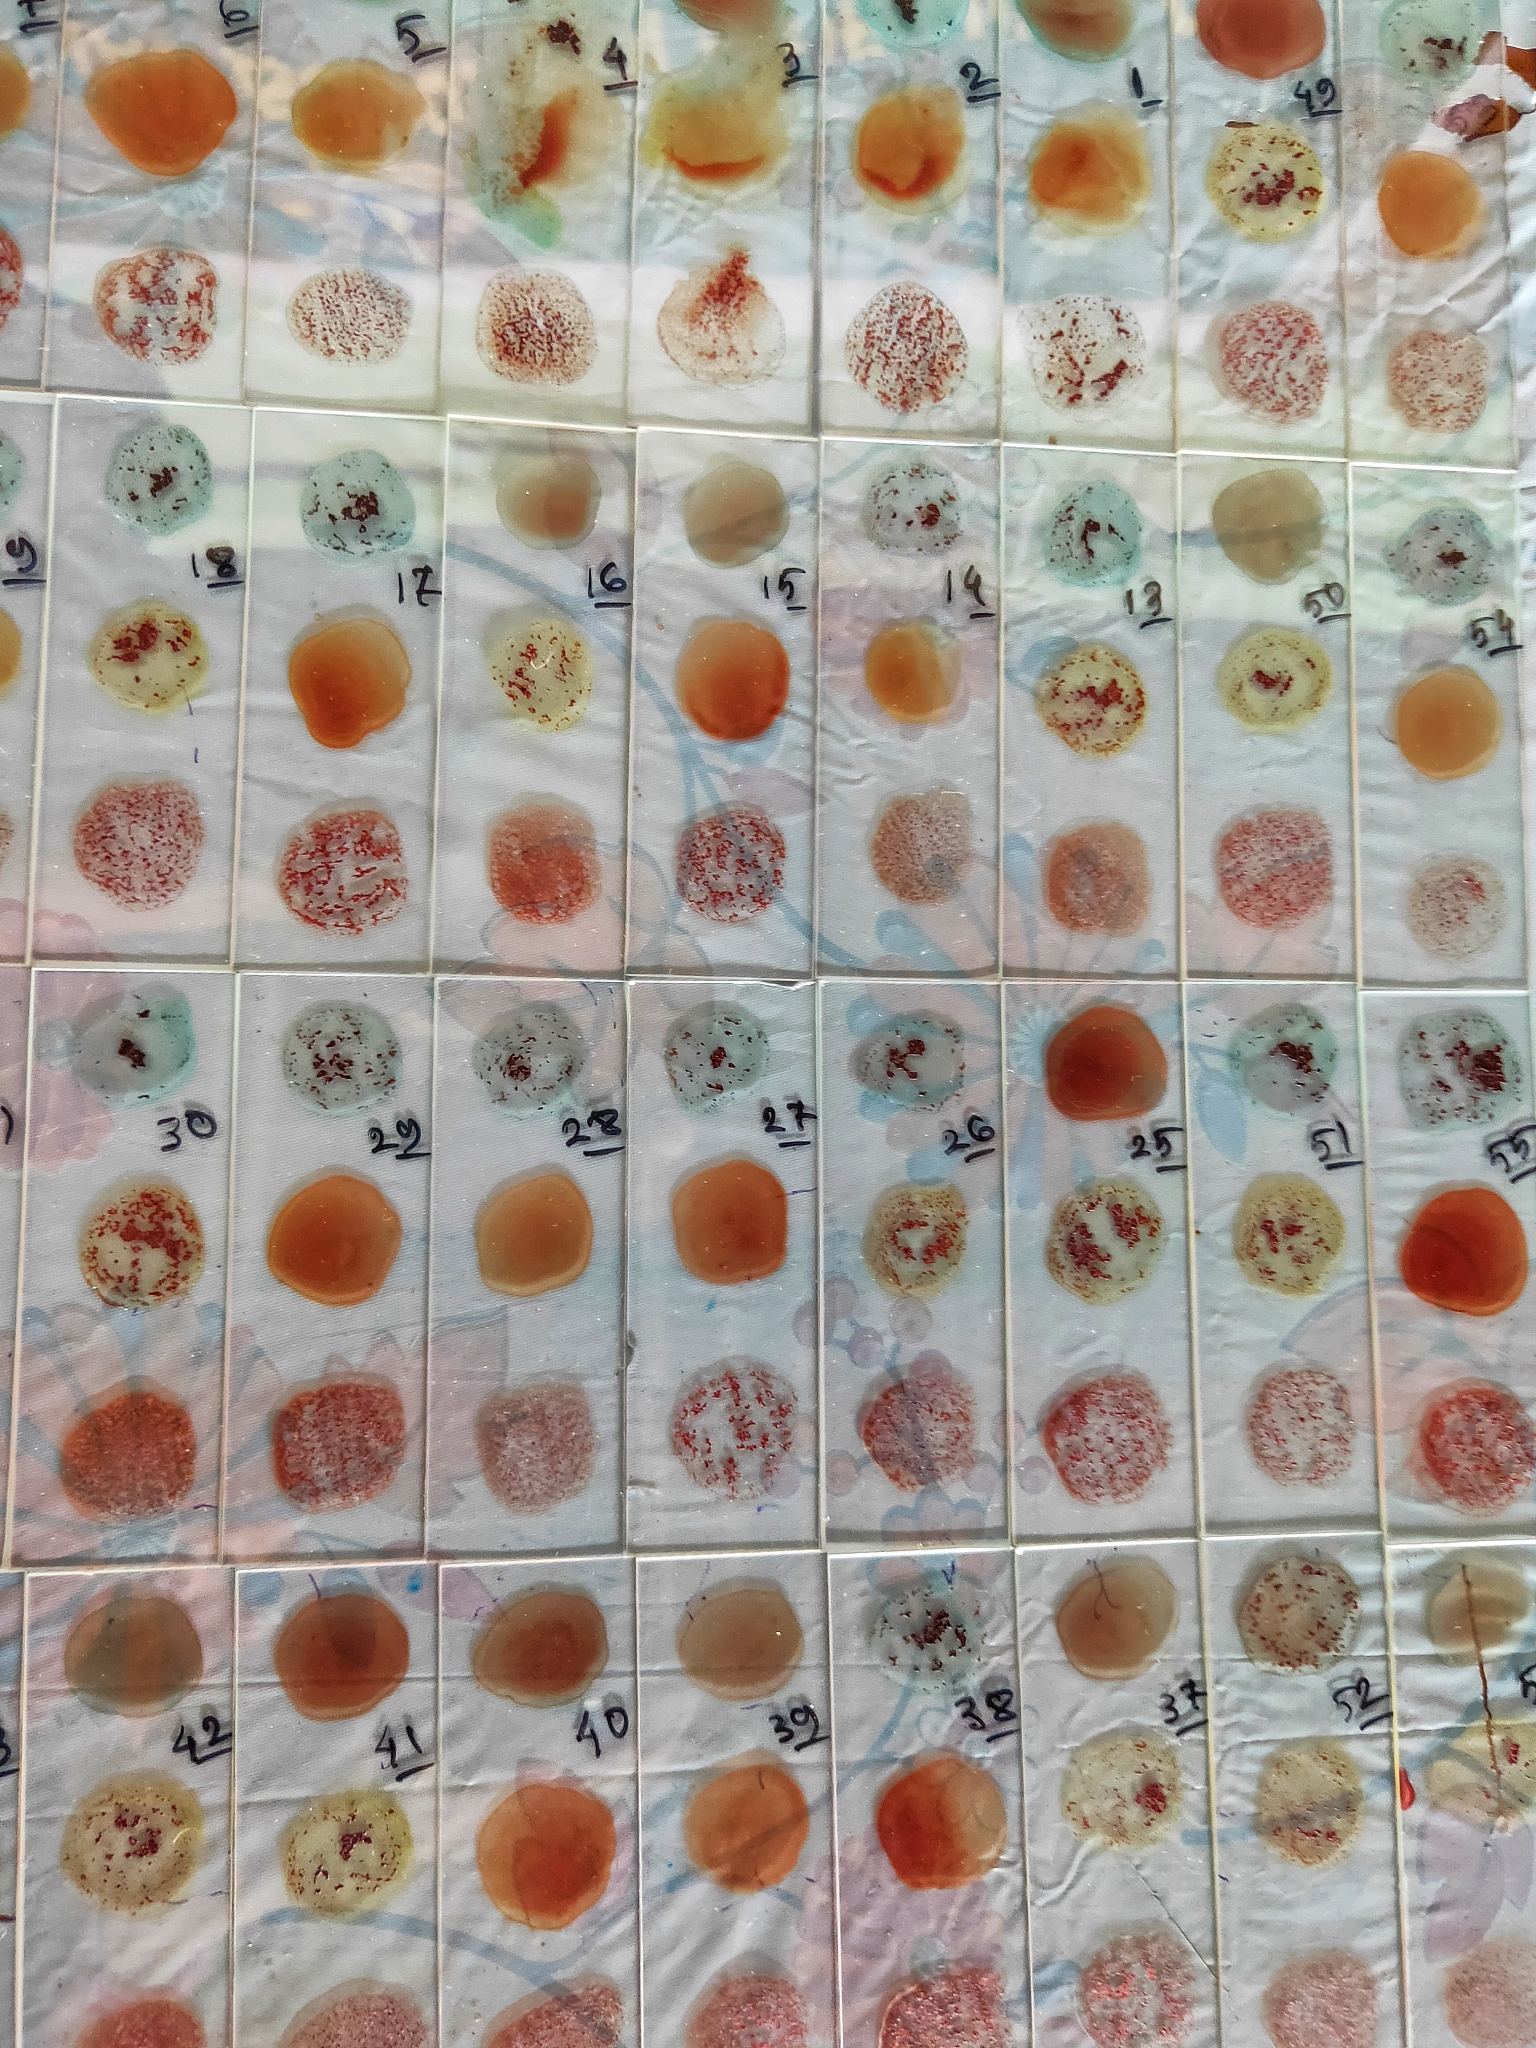
石蜡切片法脱水要怎么操作。多长时间

石蜡切片法脱水要怎么操作。多长时间
石蜡切片法是一种常用的组织学技术,其脱水操作步骤如下:
- 将组织标本在生理盐水中清洗去除血液和残留物质。
- 用70%乙醇脱水,每次脱水时间30分钟,连续脱水3次。
- 用95%乙醇脱水,每次脱水时间30分钟,连续脱水3次。
- 用绝对乙醇脱水,每次脱水时间30分钟,连续脱水3次。
- 将标本浸入绝对乙醇和液态石蜡的混合物中,每次浸泡时间30分钟,连续浸泡3次。
- 将标本浸入纯液态石蜡中,每次浸泡时间30分钟,连续浸泡3次。
- 将组织标本置于石蜡模具中,用石蜡浸泡标本,使其均匀地包裹在石蜡中。
总的脱水操作时间为6小时左右,具体时间会因组织大小和厚度而略有不同。
原文地址: https://www.cveoy.top/t/topic/bbz4 著作权归作者所有。请勿转载和采集!